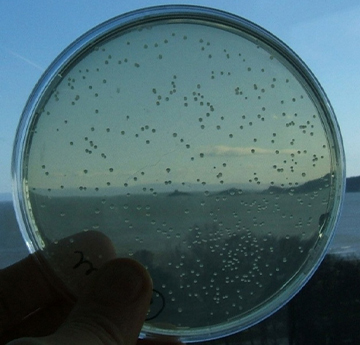

Yr Her
Bob blwyddyn, mae afiechydon ffwngaidd ledled y byd yn costio biliynau i'r diwydiant amaethyddol o ran cnydau wedi'u difa a'u difrodi. Yn yr un modd â chyffuriau gwrthffyngol ar gyfer meddygaeth, mae ffwngladdwyr hefyd yn dod yn llai effeithiol wrth i ymwrthedd gynyddu ymhlith y ffyngau a dargedir. Ym maes meddygaeth, mae baich dynol afiechydon ffwngaidd yn ddifrifol, fel yn achos graddfeydd TB neu falaria.
Y nod oedd gweithio gyda'r cwmni agrocemegol amlwladol BASF fel ei bartner byd-eang dewisol ar gyfer darganfod ffyngladdwyr a fyddai'n atal twf a/neu'n lladd yr afiechyd ffwngaidd mewn cnydau amaethyddol heb atal prosesau yn y planhigyn.
Ym maes meddygaeth, buom yn gweithio gyda Mycovia Pharmaceuticals i nodi modd gweithredu a detholedd ar gyfer ei gyffur newydd posibl a ddefnyddiwyd yn wreiddiol ar gyfer llindag rheolaidd. Mae hyn yn digwydd mewn 5-8% o fenywod, a chafodd ei gymeradwyo i'w ddefnyddio ym mis Ebrill 2022. Buom yn gweithio gyda Pulmocide Ltd i nodi dull gweithredu ei gemegyn newydd Opelconazole, sydd wedi'i gymeradwyo ar gyfer ei roi yn uniongyrchol yn ysgyfaint cleifion sydd wedi cael trawsblaniad ysgyfaint ac sydd â'r afiechyd ffwngaidd aspergilosis, sy'n peryglu bywyd.
Cafodd yr effeithiau hyn hefyd eu cefnogi gan brosiect BEACON ERDF, a ariennir gan Lywodraeth Cymru/yr UE.